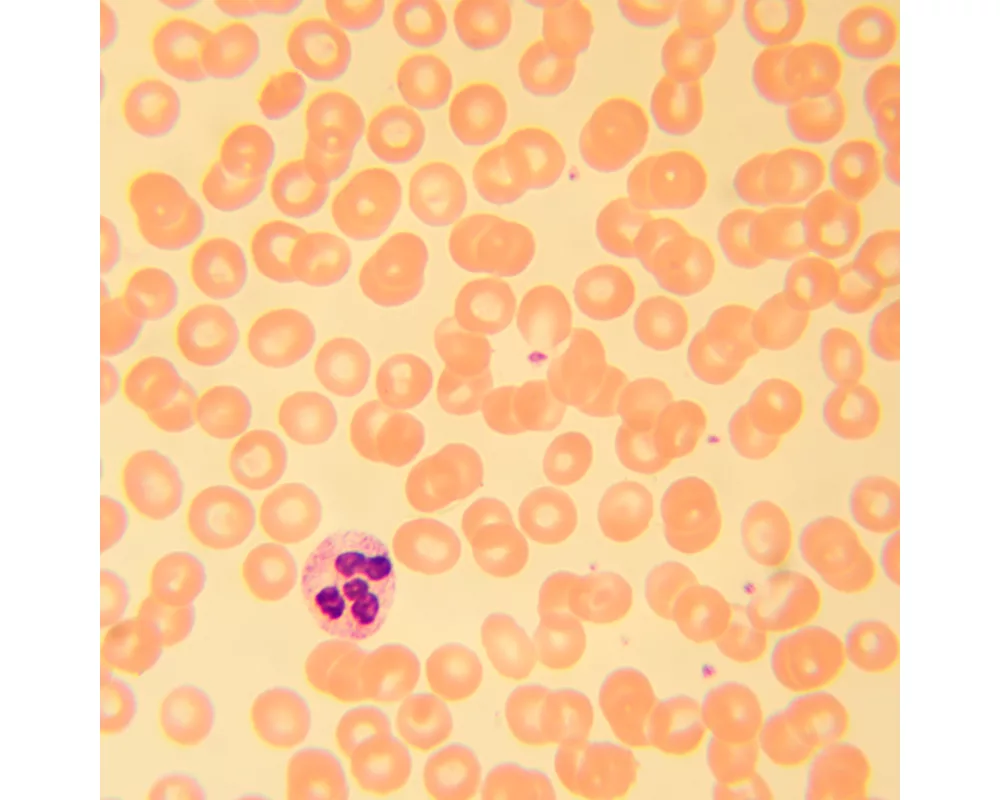
Микроскоп Биологичен цифров MAGUS Bio D230T 29

- Начало
- Оптични уреди и измервателни инструменти
- Микроскопи
- Magus
- Биологичен цифров MAGUS Bio D230T (ID: 693498)
Микроскоп Биологичен цифров MAGUS Bio D230T 83004
Плати по-лесно и сигурно с
ID: 693498
Характеристики
| Тип | биологичен, светлина/оптичен, цифрови |
| Подходящо за | лабораторно/медицинско |
| Употреба | за професионалисти, опитни потребители |
| Монтаж и инсталиране | сложен |
| Technique | на светлото поле |
| Head | глава Gemel (Siedentopf, завъртане на 360°) |
| Head angle | 30 ° |
| Revolver | за 5 обектива |
| Увеличение, x | 40 — 1000 x |
| Окуляри | 10x/18 mm, разстояние от очите: 10 mm (*опция: 10х/20 mm със скала, 15x/11 mm, 16x/11 mm; 20x/11 mm) |
| Диаметър на окуляра | 23.2 мм. |
| Диоптрична корекция на окуляра | ±5 (на лявата тръба) |
| Фокусиране | коаксиален, грубо фокусиране (21 mm, 39,8 mm/кръг, със застопоряващ бутон и бутон за регулиране на затягането) и фино фокусиране (0,002 mm) |
| Diaphragm | диафрагма с регулируема апертура, полева диафрагма с регулируем ирис |
| Objectives | ахроматични с корекция до безкрайност: 4x/0,10; 10x/0,25; 40xs/0,65; 100xs/1,25 (масло); парфокално разстояние 45 mm (*опция: 20x/0,40; 60xs/0,80) |
| Филтри | да |
| Working distance | 18,89 (4x); 5,95 (10x); 0,775 (40xs); 0,36 (100xs); 2,61/8,80 (20x); 0,46 (60хs) mm |
| Разстояние между окулярите (IPD), mm | 48 — 75 мм. |
| Condenser |
кондензер Abbe
N.A. 1,25 с регулируем център регулируема височина диафрагма с регулируема апертура слот за плъзгач за метода на тъмното поле и плъзгач за фазовоконтрастно наблюдение монтировка тип „лястовича опашка“ |
| Light source type | халогенно |
| Light source | халогенна крушка 12 V/30 W, G4 |
| Light source placement | долно |
| Spectral range | 380–650 (вграден инфрачервен филтър) nm |
| Баланс на бялото | автоматично, ръчно |
| Exposure control | автоматично, ръчно |
| Brightness control |
|
| Работна температура | 5 — 35 °С |
| Запис |
|
| Мегапиксели | 2 |
| Video format | изход: *.wmv, *.avi, *.h264 (Windows 8 и по-нова), *h265 (Windows 10 и по-нова) |
| Image format | *.jpg, *.bmp, *.png, *.tif |
| Pixel size | 3.75x3.75 μm |
| Expansion | фазовоконтрастно устройство (кондензер и обективи), кондензер за метода на тъмното поле в имерсионно масло (сух или в масло), устройства за поляризация (поляризатор и анализатор) |
| Camera power supply | постояннотоково, 5 V, от USB порта на компютър; адаптер за 12 V, 3 A за захранване на елемента на Пелтие |
| Camera operating temperature | -10 — 50 °С |
| Stage | 180x150 мм. |
| Stage adjustment | 75/50 |
| Stage features | двуосова механична предметна маса, без рейка за позициониране |
| Портове | 5 Gb/s, USB 3.0 |
| Размери на продукта | 43x27x63 cm см. |
| Системни изисквания |
Windows 8/10/11 (32-битов и 64-битов)
Mac OS X Linux до 2,8 GHz Intel Core 2 или по-мощен най-малко 2 GB RAM порт USB 3.0 CD-ROM 17" или по-голям дисплей |
| Захранване | 220±22 V, 50 Hz, променливотокова мрежа |
| Материал | плътен алуминий |
| Тегло | 11.1 kg кг. |
| Гаранция | 24 месеца |
| Код на продукта | 83004 |
Виж повече
Допълнителна информация
<p>MAGUS Bio 230T е тринокулярен биологичен микроскоп за лабораторни и изследователски наблюдения в областта на медицината, фармацевтиката, криминалистиката, биотехнологията и др. Подходящ е за наблюдение на плоски биологични полупрозрачни и прозрачни образци: тънки разрези и натривки. С оборудване от ахроматични обективи и халогенна крушка микроскопският метод с преминаваща светлина (метод на светлото поле) се използва за изследване на образци. Конструкцията на микроскопа предоставя възможност за монтиране на допълнителни принадлежности, които позволяват използването на други микроскопски методи: на тъмното поле, фазовоконтрастни наблюдения, с поляризирана светлина.</p>
<p><strong>Цифрова камера</strong></p>
<p>Цифровата камера MAGUS CDF10 е предназначена за микроскопия по метода на светлото поле и по метода на тъмното поле. Тя предлага ниско ниво на шума и висока светлочувствителност.
Камерата е оборудвана със сензор 2 MP и осигурява реалистични Full HD изображения (1920x1080 пиксела) при наблюдение с обективи 40x, 60x и 100x.
Правят се видеозаписи с максимална разделителна способност при 125 fps: те са плавни с меки и фини преходи между кадрите. Движението на пробата се показва в реално време без закъснение. Камерата улеснява работата с движещи се образци и е идеална за демонстрации в класната стая.
Камерата е снабдена с интерфейс USB 3.0. Скоростта на предаване на данни е 10 пъти по-висока от тази на камерите с USB 2.0. Високоскоростната камера се препоръчва за професионални лаборатории, изследвания или университетско обучение.</p>
<p><strong>Оптика</strong></p>
<p>Тринокулярната глава има специална вертикална тръба за монтиране на цифров фотоапарат в нея. Фотоапаратът (не е включен в комплекта) е отлично решение за създаване на цифров архив на вашите изследвания и извеждане на изображенията на екрана на външен монитор. За регулиране на наблюдателните тръби, така че да бъдат подходящи за височината на потребителя, има опция за завъртане на същите на 360°. Лявата тръба оборудвана с пръстен за регулиране на диоптъра.</p>
<p>Револверната глава е насочена навътре, което освобождава пространството над предметната маса. В револверната глава могат да се монтират едновременно пет обектива (4 обектива са включени в комплекта, а петият слот е оставен за допълнителен обектив). В базовата конфигурация коригираните до безкрайност обективи осигуряват увеличение от 40 до 1000x. Чрез допълнителни обективи горната граница може да бъде повишена до 1500, 1600, или 2000x.</p>
<p><strong>Осветление</strong></p>
<p>Халогенната крушка излъчва светлина в топлия спектър, която намалява напрежението на очите и е идеална за продължителна работа с микроскопа. Крушката е 30 W и поради това яркостта и контрастът на предаваното изображение са високи, независимо от вида на обектива или използвания метод за наблюдение.</p>
<p>Кондензерът на Abbe може да се настройва по височина и да се центрира. Осветлението се контролира чрез регулиране на ирисовата и полевата диафрагма, като има възможност за настройка на осветлението на Кьолер за по-ясно изображение. Кондензерът има слот за монтиране на плъзгач за фазоконтрастно наблюдение или такова по метода на тъмното поле, което ускорява процеса и улеснява превключването между различни микроскопски методи.</p>
<p><strong>Предметна маса и механизъм за фокусиране</strong> </p>
<p>На предметната маса няма рейка за позициониране. Това е предимство на конструкцията на механичната предметна маса, понеже улеснява работата с микроскопа. Образецът може да се премества плавно по предметната маса. Механичното приспособление може да се маха (може да се демонтира за ръчно сканиране).</p>
<p>Има грубо и фино регулиране на фокуса, движението на бутона за регулиране е плавно и лесно и не изисква допълнително усилие. Грубото фокусиране има застопоряващ механизъм и бутон за регулиране на затягането. Бутоните за фокусиране са коаксиални, разположени са така, че да осигуряват максимален комфорт при продължително наблюдение и се намират на основата на микроскопа, така че да можете да опрете удобно ръцете си върху масата.</p>
<p><strong>Принадлежности</strong></p>
<p>За да увеличите максимално възможностите на микроскопа MAGUS Bio 230T, Вие можете да го надградите с някои принадлежности. Това може да включва окуляри и обективи, цифрови фотоапарати и калибрационни образци, кондензери за метода на тъмното поле, поляризирана светлина и устройства за фазовоконтрастно наблюдение.</p>
<p><strong>Основни характеристики на микроскопа:</strong></p>
<ul>
<li>Тринокулярна глава с вертикална тръба за монтиране на цифров фотоапарат</li>
<li>Завъртането на 360° помага за регулиране на главата съобразно височината на наблюдаващия</li>
<li>Ахроматични обективи с корекция до безкрайност, револверна глава за 5 обектива</li>
<li>Пръстен за регулиране на диоптъра на лявата тръба</li>
<li>Халогенна лампа 30 W с променливотоково захранване, кондензер на Abbe, слот за плъзгач за метода на тъмното поле и плъзгач за фазовоконтрастно наблюдение, полева диафрагма</li>
<li>Бутони за грубо и фино фокусиране, застопоряващ бутон и бутон за регулиране на затягането</li>
<li>Допълнителни принадлежности за подобряване на работните характеристики на микроскопа</li>
</ul>
<p><strong>Основни характеристики на камерата:</strong></p>
<ul>
<li>За наблюдения по методите на светлото и на тъмното поле с обективи 40х, 60х, и 100х; това е най-достъпната камера за микроскопия по метода на тъмното поле със сензор с голям брой пиксели.</li>
<li>Разделителната способност на камерата е 1920x1080 пиксела: тя е идеален избор за показване на изображения на Full HD монитор.</li>
<li>125 fps за наблюдение на образци, които се движат, за видеозаписи и движение на образците без трептене и забавяне.</li>
<li>Цветният CMOS сензор SONY Exmor осигурява ниско ниво на шума и висока светлочувствителност дори при слаба осветеност. Ще получите по-ясни и по-ярки изображения с по-наситени цветове.</li>
<li>Интерфейс USB 3.0 за бързо и гладко прехвърляне на данни</li>
<li>Софтуер за запис на снимки, видеозапис, редактиране, външен дисплей, линейни и ъглови измервания</li>
</ul>
<p><strong>Комплектът включва:</strong></p>
<ul>
<li>Цифрова камера MAGUS CDF10 (цифрова камера, USB кабел, инсталационни CD с драйвери и софтуер, ръководство за потребителя и гаранционна карта)</li>
<li>Основа с вход за захранване, светлинен източник за преминаваща светлина, механизъм за фокусиране, предметна маса, кондензер и револверна глава</li>
<li>Тринокулярна глава</li>
<li>Ахроматичен обектив с корекция до безкрайност: 4x/0,1</li>
<li>Ахроматичен обектив с корекция до безкрайност: 10x/0,25</li>
<li>Ахроматичен обектив с корекция до безкрайност: 40x/0,65 (пружинно натоварен)</li>
<li>Ахроматичен обектив с корекция до безкрайност: 100x/1,25 (пружинно натоварен)</li>
<li>Окуляри 10x/18 mm с голямо разстоянието от очите (2 бр.)</li>
<li>Чашки на окулярите (2 бр.)</li>
<li>Филтри (4 бр.)</li>
<li>Адаптер за камера с С-образна монтировка</li>
<li>Бутилка с имерсионно масло</li>
<li>Шестостенен ключ</li>
<li>Променливотоково захранване</li>
<li>Покривало против прах</li>
<li>Ръководство за потребителя и гаранционна карта</li>
</ul>
<p><strong>Предлагат се по заявка:</strong></p>
<ul>
<li>Окуляр 15x/11 mm (2 бр.)</li>
<li>Окуляр 16x/11 mm (2 бр.)</li>
<li>Окуляр 20x/11 mm (2 бр.)</li>
<li>Ахроматичен обектив с корекция до безкрайност: 20x/0,4</li>
<li>Фазовоконтрастно устройство</li>
<li>Плъзгач за фазовоконтрастно наблюдение</li>
<li>Кондензер за тъмно поле NA 0,9</li>
<li>Кондензер за метода на тъмното поле в имерсионно масло NA 1,36–1,25</li>
<li>Плъзгач за метода на тъмното поле</li>
<li>Устройство за поляризация</li>
<li>Калибрационен образец</li>
</ul>
Виж повече
Допълнителна информация
Виж повече
Информация за производителя
| Контакт | [email protected] |
| Адрес | ул. Акад. Стефан Младенов 46, София, 1700, България |
| Уебсайт | https://magusmicro.bg/ |
Виж повече
Ние от PIC.bg постоянно полагаме усилия информацията на тази страница да е точна. В редки случаи съдържанието може да е некоректно. Всички снимки са с информативна цел и е възможно да съдържат аксесоари, които не са включени в стандартния пакет. Някои от спецификациите или цените могат да бъдат променяни от производителя без предизвестие или да съдържат експлоатационни грешки. Всички промоции, посочени в сайта, се предлагат до изчерпаване на количествата.
Отзиви
0.0
0 отзива.
5
0
4
0
3
0
2
0
1
0
Оцени продукта
Добави отзив